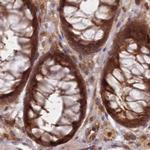
GBE1 Antibody in Immunohistochemistry (IHC)

Search
Invitrogen
GBE1 Polyclonal Antibody
{{$productOrderCtrl.translations['antibody.pdp.commerceCard.promotion.promotions']}}
{{$productOrderCtrl.translations['antibody.pdp.commerceCard.promotion.viewpromo']}}
{{$productOrderCtrl.translations['antibody.pdp.commerceCard.promotion.promocode']}}: {{promo.promoCode}} {{promo.promoTitle}} {{promo.promoDescription}}. {{$productOrderCtrl.translations['antibody.pdp.commerceCard.promotion.learnmore']}}
产品信息
PA5-58237
种属反应
宿主/亚型
分类
类型
抗原
偶联物
形式
浓度
规格
纯化类型
保存液
内含物
保存条件
运输条件
RRID
产品详细信息
Immunogen sequence: GENEGGIDKF SRGYESFGVH RCADGGLYCK EWAPGAEGVF LTGDFNGWNP FSYPYKKLDY GKWELYIPPK QNKSVLVP
Highest antigen sequence identity to the following orthologs: Mouse - 88%, Rat - 87%.
靶标信息
GBE1 is a glycogen branching enzyme that catalyzes the transfer of alpha-1,4-linked glucosyl units from the outer end of a glycogen chain to an alpha-1,6 position on the same or a neighboring glycogen chain. Branching of the chains is essential to increase the solubility of the glycogen molecule and, consequently, in reducing the osmotic pressure within cells. Highest level of this enzyme are found in liver and muscle. Mutations in this gene are associated with glycogen storage disease IV (also known as Andersen's disease).
仅用于科研。不用于诊断过程。未经明确授权不得转售。
篇参考文献 (0)
生物信息学
蛋白别名: 1,4-alpha-glucan-branching enzyme; amylo-(1,4 to 1,6) transglucosidase; amylo-(1,4 to 1,6) transglycosylase; Brancher enzyme; glucan (1,4-alpha-), branching enzyme 1; glycogen branching enzyme; Glycogen-branching enzyme; unnamed protein product
基因别名: APBD; GBE; GBE1; GSD4
UniProt ID: (Human) Q04446
Entrez Gene ID: (Human) 2632, (Rat) 288333